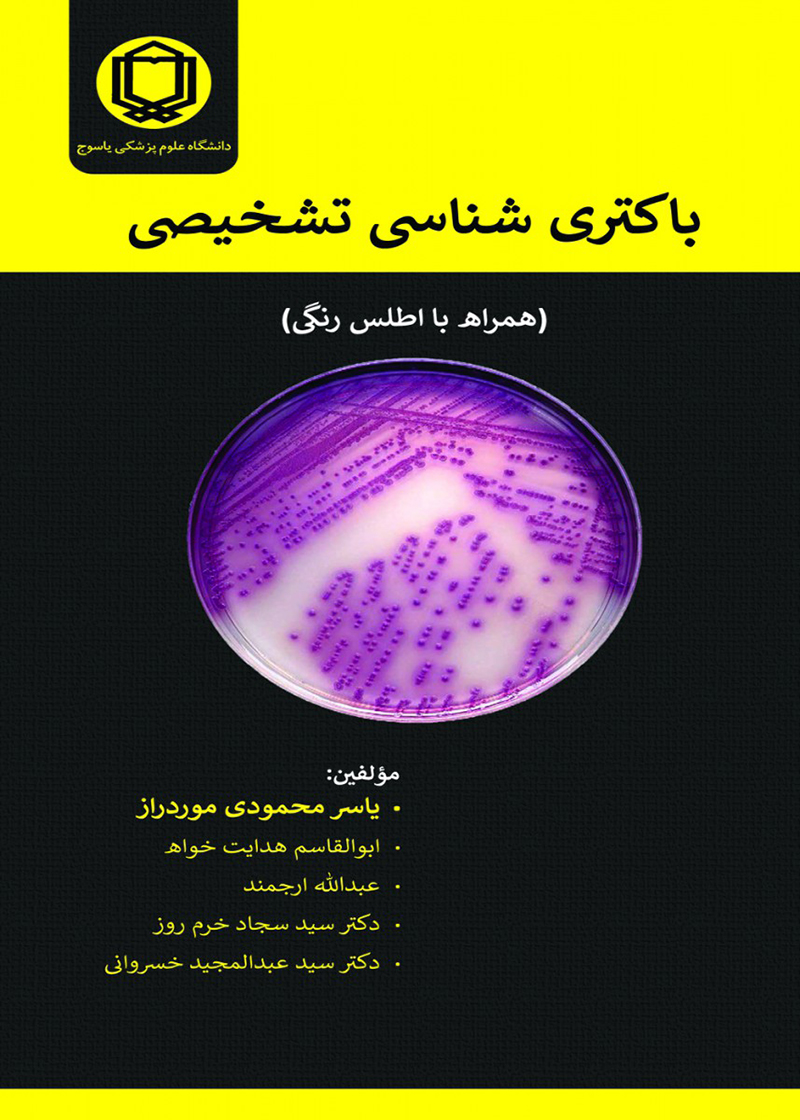

کتاب باکتری شناسی تشخيصی همراه با اطلس رنگی یاسر محمودی موردراز
(901)
دسته بندی : پاتولوژی - آسیب شناسی
نویسنده : یاسر محمودی موردراز
انتشارات : انتشارات حیدری
سال چاپ : 1398
نوبت چاپ : اول
قطع : وزیری
شابک : 978521254
تعداد صفحه 531 انتشارات حیدری تألیف یاسر محمودی موردراز و همکاران
-
ارسال سریع
ارسال سریع با پست
-
پرداخت امن
پرداخت از طریق درگاه های بانکی
کتاب باکتری شناسی تشخيصی همراه با اطلس رنگی یاسر محمودی موردراز
کد p00965
تعداد صفحه 531
وزن 800
تألیف محمد تقی آساد
انتشارات حیدری
چاپ اول
سال 1399
موضوعات
باکتری شناسی
| عنوان کتاب | کتاب باکتری شناسی تشخيصی همراه با اطلس رنگی یاسر محمودی موردراز |
|---|---|
| گروه کتاب | پاتولوژی - آسیب شناسی |
| نویسنده | یاسر محمودی موردراز |
| مترجم | |
| شابک | 978521254 |
| قطع کتاب | وزیری |
| تاریخ انتشار | 1398 |
| ناشر | انتشارات حیدری |
| سال چاپ | 1398 |
| نوبت | اول |
| تگ ها | باکتری شناسی باکتری های بیماری زا تشخیص باکتری ها |
نظرات کاربران
0
0 رای